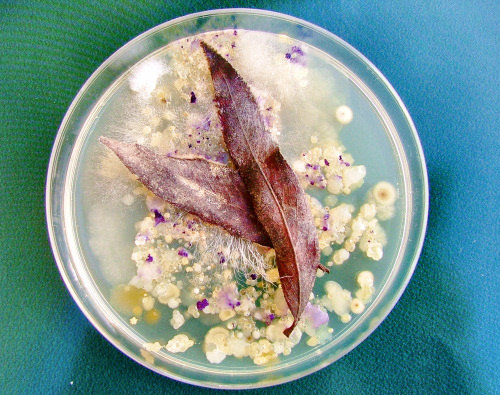
Image1.jpg

| Autore |
Messaggio |
Zio Cane
utente attivo

Iscritto: 12 Set 2004
Messaggi: 501
Località: Roma
|
 Inviato: Sab 27 Mgg, 2006 10:32 pm Oggetto: Brulicante di vita Inviato: Sab 27 Mgg, 2006 10:32 pm Oggetto: Brulicante di vita |
 |
|
Dopo circa 6 mesi sono riuscito a ripostare 
Suggerimenti e critiche sempre ben accetti
Ciao grazie! 
_________________
<<--- Zio Cane --->>
Canon EOS 5D; BG-E4; Canon EOS 20D; BG-E2; 2 Flash Canon 550 EX; Canon EF 24-70mm f/2.8 L; Canon EF 75-300 f/4.5-5.6 IS; Sigma 12-24mm f/4.5-5.6; Sigma 15-30mm f/3.5-4.5; Sigma 70-200mm f/2.8; |
|
Vai ad inizio pagina
Vai a fine pagina |
|
 |
Muad'Dib
utente attivo

Iscritto: 26 Lug 2004
Messaggi: 16431
Località: Trapani
|
 Inviato: Sab 27 Mgg, 2006 10:37 pm Oggetto: Inviato: Sab 27 Mgg, 2006 10:37 pm Oggetto: |
 |
|
Bei colori e bella composizione, ma . . . che cavolo è ??? 
Non riesco a capire se è una macro dello yogurt scaduto e che altro.
Enzo 
_________________
Canon eos 6D | EF 50/1.8 | EF 20-35 3,5-4,5 | EF 28-135 IS 3,5-5,6 | PHOTOSHOP: La Miniguida
Yashica FX7 | Contax 139Q | Mir 20/3,5 | ML 28/2,8 | DSB 50/1,9 | Planar 50/1,7 | ML 135/2,8 | |
|
Vai ad inizio pagina
Vai a fine pagina |
|
 |
Zio Cane
utente attivo

Iscritto: 12 Set 2004
Messaggi: 501
Località: Roma
|
 Inviato: Sab 27 Mgg, 2006 10:55 pm Oggetto: Inviato: Sab 27 Mgg, 2006 10:55 pm Oggetto: |
 |
|
| Muad'Dib ha scritto: | Bei colori e bella composizione, ma . . . che cavolo è ??? 
Non riesco a capire se è una macro dello yogurt scaduto e che altro.
Enzo  |
Grazie 
yogurt scaduto...... diciamo che ci sei vicino.... 
_________________
<<--- Zio Cane --->>
Canon EOS 5D; BG-E4; Canon EOS 20D; BG-E2; 2 Flash Canon 550 EX; Canon EF 24-70mm f/2.8 L; Canon EF 75-300 f/4.5-5.6 IS; Sigma 12-24mm f/4.5-5.6; Sigma 15-30mm f/3.5-4.5; Sigma 70-200mm f/2.8; |
|
Vai ad inizio pagina
Vai a fine pagina |
|
 |
lusy 49
utente

Iscritto: 26 Feb 2006
Messaggi: 240
Località: Roma
|
 Inviato: Sab 27 Mgg, 2006 10:59 pm Oggetto: Inviato: Sab 27 Mgg, 2006 10:59 pm Oggetto: |
 |
|
Foto strana ma bei colori.  Ci svelerai l'oggetto misterioso? Ci svelerai l'oggetto misterioso?
_________________
ciao Lusy
Canon PS-S80 |
|
Vai ad inizio pagina
Vai a fine pagina |
|
 |
Zio Cane
utente attivo

Iscritto: 12 Set 2004
Messaggi: 501
Località: Roma
|
 Inviato: Sab 27 Mgg, 2006 11:20 pm Oggetto: Inviato: Sab 27 Mgg, 2006 11:20 pm Oggetto: |
 |
|
| lusy 49 ha scritto: | Foto strana ma bei colori.  Ci svelerai l'oggetto misterioso? Ci svelerai l'oggetto misterioso? |
grazie.
Per l'oggetto non credo sia difficile da indovinare... dal titolo si dovrebbe evincere facilmente 
_________________
<<--- Zio Cane --->>
Canon EOS 5D; BG-E4; Canon EOS 20D; BG-E2; 2 Flash Canon 550 EX; Canon EF 24-70mm f/2.8 L; Canon EF 75-300 f/4.5-5.6 IS; Sigma 12-24mm f/4.5-5.6; Sigma 15-30mm f/3.5-4.5; Sigma 70-200mm f/2.8; |
|
Vai ad inizio pagina
Vai a fine pagina |
|
 |
Muad'Dib
utente attivo

Iscritto: 26 Lug 2004
Messaggi: 16431
Località: Trapani
|
 Inviato: Sab 27 Mgg, 2006 11:38 pm Oggetto: Inviato: Sab 27 Mgg, 2006 11:38 pm Oggetto: |
 |
|
| Zio Cane ha scritto: | ... dal titolo si dovrebbe evincere facilmente  |
No !!!
Comincio ad avere un brutto sospetto.
Non dirmi che è quello a cui sto pensando in questo momento.
Nooo, non ci credo, non l'avrai fatto davvero ???
Enzo 
_________________
Canon eos 6D | EF 50/1.8 | EF 20-35 3,5-4,5 | EF 28-135 IS 3,5-5,6 | PHOTOSHOP: La Miniguida
Yashica FX7 | Contax 139Q | Mir 20/3,5 | ML 28/2,8 | DSB 50/1,9 | Planar 50/1,7 | ML 135/2,8 | |
|
Vai ad inizio pagina
Vai a fine pagina |
|
 |
Arthas
utente attivo

Iscritto: 29 Mar 2006
Messaggi: 1334
Località: Caltabellotta (AG)
|
 Inviato: Dom 28 Mgg, 2006 1:05 am Oggetto: Inviato: Dom 28 Mgg, 2006 1:05 am Oggetto: |
 |
|
Ciao Enzo, ma se fosse quello che pensi tu (e che forse sto pensando anch'io) come fa ad essere di questo colore!?!?!? 
_________________
Giuseppe Parinisi
Canon EOS 350D DIGITAL + BG-E3, EF-S 18-55mm + EW-60C, EF 55-200mm + ET-54, EF 50mm + ES-62-L, Metz mecablitz 44 AF-4 C digital
Una foto non scattata è un ricordo che non c'è. |
|
Vai ad inizio pagina
Vai a fine pagina |
|
 |
Zio Cane
utente attivo

Iscritto: 12 Set 2004
Messaggi: 501
Località: Roma
|
 Inviato: Dom 28 Mgg, 2006 10:09 am Oggetto: Inviato: Dom 28 Mgg, 2006 10:09 am Oggetto: |
 |
|
 O mio *io santissimo, NO!!!! Assolutamente no!!! O mio *io santissimo, NO!!!! Assolutamente no!!!
Muad e Arthas, sono matto ma non pervertito 
Bè.... comunque ci siete vicinissimissimi
PS: Gli spermatozoi non sono considerati esseri viventi in quanto non svolgono le 5 funzioni che un essere vivente deve compiere per essere considereto tale! 
PS del PS: aoooo ma ste critiche? 
_________________
<<--- Zio Cane --->>
Canon EOS 5D; BG-E4; Canon EOS 20D; BG-E2; 2 Flash Canon 550 EX; Canon EF 24-70mm f/2.8 L; Canon EF 75-300 f/4.5-5.6 IS; Sigma 12-24mm f/4.5-5.6; Sigma 15-30mm f/3.5-4.5; Sigma 70-200mm f/2.8; |
|
Vai ad inizio pagina
Vai a fine pagina |
|
 |
Iridielle
nuovo utente
Iscritto: 10 Mgg 2006
Messaggi: 39
Località: Torino
|
 Inviato: Dom 28 Mgg, 2006 10:40 am Oggetto: Inviato: Dom 28 Mgg, 2006 10:40 am Oggetto: |
 |
|
Sembra tanto una coltura di muffe.
Strana foto, ma bella.
Ciao
_________________
Silvia |
|
Vai ad inizio pagina
Vai a fine pagina |
|
 |
franco meloni
utente attivo
Iscritto: 12 Apr 2006
Messaggi: 1270
|
 Inviato: Dom 28 Mgg, 2006 12:20 pm Oggetto: Inviato: Dom 28 Mgg, 2006 12:20 pm Oggetto: |
 |
|
Il viola e le texture ( tipo tessuto ) mi depistano
. ! Ho avuto un impatto buono
 ma ora che penso alle muffe o roba strana
non è che sia felicissimo ma ora che penso alle muffe o roba strana
non è che sia felicissimo

Ps : Fuori argomento : sul non sono considerati esseri viventi .. avrei forte dubbio
Ciao franco
|
|
Vai ad inizio pagina
Vai a fine pagina |
|
 |
Zio Cane
utente attivo

Iscritto: 12 Set 2004
Messaggi: 501
Località: Roma
|
|
Vai ad inizio pagina
Vai a fine pagina |
|
 |
franco meloni
utente attivo
Iscritto: 12 Apr 2006
Messaggi: 1270
|
 Inviato: Dom 28 Mgg, 2006 3:44 pm Oggetto: Inviato: Dom 28 Mgg, 2006 3:44 pm Oggetto: |
 |
|
Interessante ! sembra pure appetitosa
. in quale Ristorante la servonooooo?
Ps : curiosità :
..dal blu della Escherichia si producono
coloranti per tessuti
.ultimamente jeans !
|
|
Vai ad inizio pagina
Vai a fine pagina |
|
 |
|












 O mio *io santissimo, NO!!!! Assolutamente no!!!
O mio *io santissimo, NO!!!! Assolutamente no!!!



 In particolare:
In particolare: